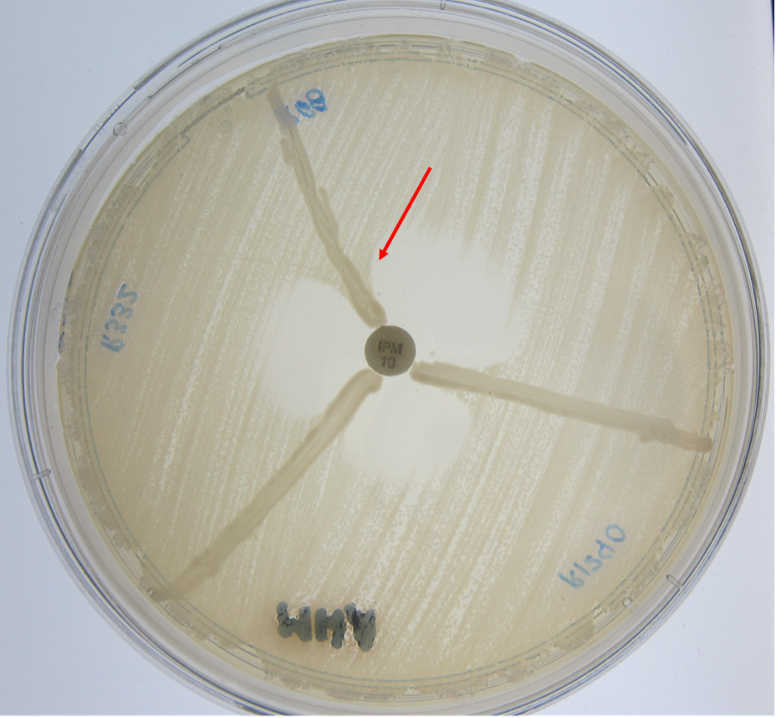
SciEnggJ%202024%20Special%20Issue%201 7 Pasham%20et%20al

SciEnggJ 17 (Supplement) 089-095
available online: March 25, 2024
DOI: https://doi.org/10.54645/202417SupXYS-32
*Corresponding author
Email Address: addelatonga@up.edu.ph
Date received: December 13, 2023
Date revised: February 12, 2024
Date accepted: February 20, 2024
Molecular characteristics of carbapenem-resistant Enterobacteriaceae isolated from two tertiary hospitals in the Philippines
Species belonging to the family Enterobacteriaceae cause infections that result in clinically significant morbidity and mortality. These organisms have been shown to harbor multiple mechanisms of resistance to antibiotics, including carbapenems. Molecular characterization of resistance to carbapenems is critical since few effective therapeutic options exist, most of which are difficult to access in resource-limited settings. One hundred twenty-six Enterobacteriaceae isolates with phenotypic resistance to at least one carbapenem were collected from two tertiary hospitals in the Philippines from 2014 to 2016. The organisms were screened for the presence of genes coding for carbapenemases and extended spectrum β-lactamases (ESBLs) using multiplex PCR. Multilocus sequence typing (MLST) was performed for Klebsiella pneumoniae, Escherichia coli and Enterobacter cloacae complex. The majority of the carbapenem-resistant isolates were K. pneumoniae (70/126, 55.5%) followed by K. ozaenae (19/126, 15%). Amplification of genes conferring carbapenem resistance showed blaNDM in 89 isolates (70%), followed by blaKPC in 21 isolates (16%). MLST revealed the presence of different clones including ST16 (5/70), ST17 (3/70) and ST147 (9/70) in K. pneumoniae, and ST10 (3/13) in E. coli. This study shows that blaNDM is the most prevalent carbapenemase type among carbapenem-resistant Enterobacteriaceae (CRE). Presence of carbapenemase gene and multiple ESBLs in the same organism pose a risk in the clinical setting since it could confer higher antibiotic resistance. This high rate of resistance poses the risk of spread since it can be transferred by mobile genetic elements. This study illustrates the acute need for effective therapeutic and hospital infection controls against CREs.
© 2026 SciEnggJ
Philippine-American Academy of Science and Engineering